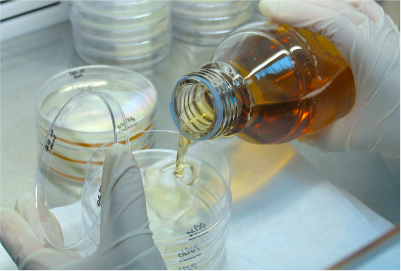
CONTROL CALIDAD

Buen día, por favor escríbenos al whatsApp: +573185936262, para inquietudes.
PBX: (57) 601 5145821
Recepción: (57) 3184873767
Fijo Servicio al cliente: (57) 601 2905898 - (57) 601479 6652
Servicio al cliente: (57) 3185936262
Recepción: (57) 3184873767
Fijo Servicio al cliente: (57) 601 2905898 - (57) 601479 6652
Servicio al cliente: (57) 3185936262

TECMOL FARMACÉUTICA S.A.S.
Cra. 71D No. 6D-59/53
Barrio Marsella Bogotá D.C. – Colombia
PBX: (57) 601 5145821
Recepción: (57) 3184873767
Fijo Servicio al cliente: (57) 601 2905898 - (57) 601479 6652
Servicio al cliente: (57) 3185936262
AREAS:
Toxicologia: (57) 3158491380 - (57) 3188032257
Toxicologia: (57) 3158491380 - (57) 3188032257
Ecotoxicologia: (57)3162294071
Asuntos Regulatorios: (57) 3158491380 - (57) 3188032257
©
2026
TECMOL FARMACEUTICA S.A.S